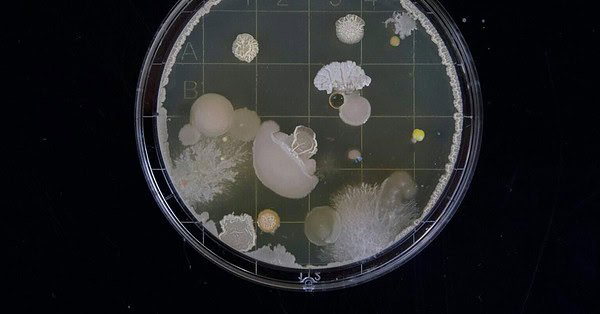
A petri dish covered in bacterial/fungal colonies growing on the agar in front of a black background

Tag: CDC
Oropouche: How Concerned Should We be?
In 1955, a forest worker in Trinidad and Tobago contracted a fever. The worker recovered fully, though the disease persisted, with outbreaks occurring in northern South America and nearby coastal islands. The movements of humans pose challenges for those hoping to reduce the risks associated with any infectious agent, as is the case with the ...Lassa Fever Suspected in Traveler’s Death
The Centers for Disease Control opened an investigation into the death of a traveler upon returning home to Iowa from West Africa. Previously, reports stated that the traveler died of an “Ebola-like” virus. Further Nebraska Laboratory Response Network testing confirmed that the patient tested positive for Lassa fever. Lassa Fever Lassa fever occurs in West ...The CDC BEAM Dashboard
Every year, the United States faces microbial pathogen outbreaks caused by amoebas, bacteria, and other microorganisms. These outbreaks manifest in a variety of diseases, ranging from gastrointestinal distress to brain-eating amoebae. As mentioned in my previous article, the Centers for Disease Control (CDC) gathers data on infections resulting in hospitalizations and provides access to this ...Scary No More: ArboNet
The news cycle instills fear in the anxious. The zombie apocalypse might be just around the corner, right? Since the global pandemic of COVID-19, the public consciousness of viruses has gravitated toward panic. From Monkey Pox to West Nile Virus, every “outbreak” traps some people inside their homes, afraid to leave. With risk assessment, this ...Is Trump Censoring America?
With everything going on in the world, I sit on my soft burgundy couch in a constant state of confusion. Trump is tweeting about the fake news when he should be worried about his fake tan. Now, I understand living in the Digital Age means one needs to be sure of their source of information, ...